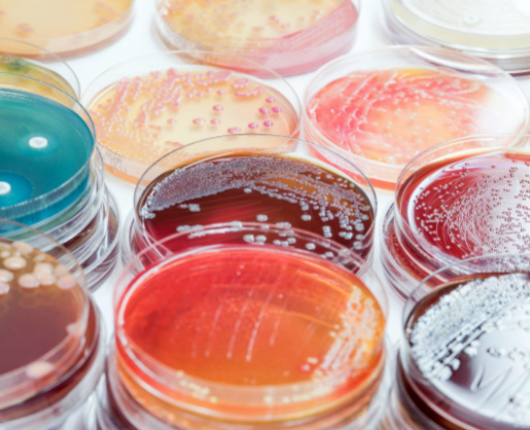
Laboratorul de infecţii Intraspitaliceşti

Centrul are în comonenţa sa 4 laboratoare și are ca sarcină elaborarea şi implementarea de medicamente noi sau reproduse preponderent în baza materiei prime locale.

- Acasă
- Laboratoare
- Laboratoare
Laboratoare
Centrul de Cultivare a Plantelor Medicinale a fost fondat în anul 2002, actualmente ocupă o suprafaţă totală de 13 ha, fiind situat la 4 km N-E de comuna Bardar, r-nul Ialoveni. Pe acest teren a fost creată o colecţie de plante medicinale
Pe parcursul a 27 ani de activitate au fost realizate cercetări de amploare, axate pe cele mai importante probleme ale alergologiei şi imunologie.
Cercetările efectuate au fost axate pe studiul modificărilor markerilor remodelării osoase, în ţesutul osos şi organele de importanţă vitală (rinichi, ficat) în diverse stări patologice.
Cercetările ştiinţifice sunt axate pe studierea factorilor de risc din cadrul sindromului metabolic și anume a bolilor cardiovasculare şi complicaţiile acestora (moartea subită, infarctul miocardic fatal sau nonfatal şi accidentul vascular cerebral).
Direcţia principală a studiului realizat în laborator este transplantarea valvelor cardiace decelularizate, care sunt tolerate de către sistemul imunitar al pacientului, inclusiv copii, cu potentialul de a creşte împreună cu pacientul.
Au fost efectuate cercetări axate pe unele dintre cele mai actuale probleme ale chirurgiei zonei hepato-pancreato-biliare. Au fost implementate în practica medicală cotidiană noi metode de tratament chirurgical a afecţiunilor hepato-pancreato-biliare.
Activitatea de cercetare este orientată spre elucidarea mecanismelor etiopatogenetice ale afecţiunilor chirurgicale ale tractului digestiv, evaluarea metodelor moderne de diagnostic şi tratament contemporan chirurgical.
Pe parcursul a 4 ani de activitate s-au efectuat cercetări pe cele mai importante probleme ale endocrinologiei şi diabetologiei.
Pe parcursul a 20 de ani de activitate au fost studiaţi factorii de risc în apariţia şi progresarea maladiilor cronice ale ficatului şi elaborarea metodelor optime de diagnostic, tratament, profilaxie primară şi secundară, în scopul reducerii mortalităţii
Pe parcursul anilor s-au efectuat cercetări axate pe stabilirea markerilor molecular-genetici în prevenirea patologiilor cardio-vasculare, oncologice, metabolice.
S-au efectuat cercetări axate pe cele mai importante probleme ale gerontologiei: particularităţile senescenţei populaţiei, elaborarea şi implementarea metodelor noi de diagnostic, tratament şi profilaxie a patologiilor cardiovasculare la vârstnici.
Pe parcursul activităţii s-au efectuat cercetări de amploare axate pe cele mai importante probleme ale chirurgiei pediatrice, abordând o gamă largă de intervenţii chirurgicale
Au fost studiate circa 2000 de substanţe indigene noi de origine sintetică şi naturală, depistate mai bine de 250 de substanţe biologic active, din care 40 au fost brevetate. Elaborate 4 preparate antibacteriene şi antifungice noi, 2 medii nutritive sel
Transplantarea de celule umane sau animale pentru înlocuirea sau repararea ţesuturilor sau celulelor deteriorate cît și inserţia genelor într-o celulă individuală sau ţesut biologic cu scop de tratament ale maladiilor.
Pe parcursul activităţii s-au efectuat cercetări de amploare axate pe cele mai importante probleme ale chirurgiei pediatrice, abordând o gamă largă de intervenţii chirurgicale.
Au fost studiate circa 2000 de substanţe indigene noi de origine sintetică şi naturală, depistate mai bine de 250 de substanţe biologic active, din care 40 au fost brevetate. Elaborate 4 preparate antibacteriene şi antifungice noi, 2 medii nutritive sel
Pe parcursul activităţii laboratorul s-a ocupat de evidențierea factorilor de risc, ce predispun la inițierea timpurie a consumului de substanțe psihoactive, inclusiv alcool, printre tineretul studios.
Pe parcursul activităţii s-au efectuat cercetări de amploare axate pe cele mai importante probleme ale chirurgiei pediatrice, abordând o gamă largă de intervenţii chirurgicale
Au fost studiate circa 2000 de substanţe indigene noi de origine sintetică şi naturală, depistate mai bine de 250 de substanţe biologic active, din care 40 au fost brevetate. Elaborate 4 preparate antibacteriene şi antifungice noi, 2 medii nutritive sel